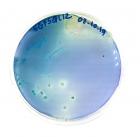

Основные научные направления секции: структурная биология, физико-химичекая биология, молекулярная биология, биотехнология, разработка лекарственных средств

Задача многоцелевого анализа биологических образцов и идентификации в них отдельных соединений стоит перед многими медицинскими организациями. Часто используемым, наиболее точным и высокочувствительным методом, применяемым для подобного рода анализов, является масс-спектрометрия высокого разрешения. В данной работе предложен метод, совмещающий реакцию изотопного обмена кислорода с масс-спектрометрией; метод позволяет повысить достоверность идентификации отдельных соединений.

Четыре клеточные линии (здоровые и опухолевые клетки молочной железы и лёгких) содержатся в питательной среде, обработанной холодной плазмой. Под действием холодной плазмы в растворе образуются нитриты, нитраты и пероксид водорода, их концентрация зависит от времени обработки. Жизнеспособность клеток зависит от процента разведения обработанной питательной среды и времени обработки. Зарегистрирована селективность для клеток молочной железы: жизнеспособность опухолевых клеток на 40 % ниже.

Исследование наноразмерных биологических объектов – митохондрий, является актуальной научно-исследовательской задачей, которая на основании определения морфологии, текстуры и движения данных объектов позволяет характеризовать их различные биологические свойства с целью выявления биомедицинских показателей органов и тканей, из которых объекты были получены. В представленной работе рассматривается исследование митохондрий методами сканирующей зондовой микроскопии

Микроорганизмы - компонент биогеохимического барьера, препятствующие распространению загрязнителей в подземных водах. В работе исследуются механизмы микробной адгезии на барьерных материалах.

Нарушения в уровнях экспрессии нейротрофинов могут приводить к различным пагубным проявлениям, таким как болевой синдром, возникновение агрессии, депрессии, зависимости от наркотических веществ и прочим. Рецепторы нейротрофинов - ключевая мишень для перспективной терпаии этих состояний. В данной работе изучены структурные особенности и динамика примембранного региона рецептора TrkA с целью понимания механизма его активации фактором роста нейронов (NGF).

Толл-подобные рецепторы являются ключевыми участниками врожденного иммунного ответа и могут служить мишенями против воспалительных, нейродегеративных и аутоиммунных заболяеваний. В данной работе изучены структура, динамика и металлсвязывающая способность внутриклеточного домена рецептора TLR1 с целью уточнения механизма внутриклеточной активации комплекса TLR1/TLR2.

В настоящей работе мы сообщаем об антибактериальном гидрогеле, полученном путем гелеобразования нанокристаллов целлюлозы с аминокислотными жидкостями. По сравнению с большинством раневых повязок с антибактериальными агентами, наш гель подавлял рост различных типов бактерий. Антибактериальная активность была достигнута без каких-либо антибактериальных поверхностных агентов или антибиотиков, в то же время наш гидрогель показал высокий уровень биосовместимости и низкий уровень цитотоксичности.

В данной работе проведено сравнение использования методов полимеразной цепной реакции и изотермической амплификации для обнаружения РНК SARS-CoV-2 в мазках из рото- и носоглотки. Протестирован 381 образец, и показано различие в скорости получения результата, а также в применимости указанных методов для образцов с различной вирусной нагрузкой.

Для оценки долговременной безопасности инженерных материалов необходимо учитывать комплексное воздействие физических, химических и микробиологических процессов. Природные глины являются источниками биофильных элементов и органических веществ, необходимых для развития микроорганизмов. Поэтому необходимо уделять должное внимание вопросам их микробной трансформации. В связи с этим целью данной работы стала разработка методики оценки биоопасности инженерных материалов.

Lynx2 — важный модулятор ЦНС, участвующий в холинергическом контроле тревожности. Высокий уровень экспрессии Lynx2 отмечается в таламусе, миндалине и префронтальной коре. Ключевой мишенью Lynx2 является α4β2-холинорецептор — связываясь с аллостерическим α4/α4-интерфейсом, Lynx2 усиливает десенситизацию и подавляет ионную проводимость. В настоящей работе рассматриваются аспекты межмолекулярого взаимодействия Lynx2 с α4β2-холинорецептором.

Рецептор SORCS2 играет важную роль в жизнедеятельности нейронов. Патологии в его функционировании связаны с различными психическими и нейродегенеративными заболеваниями, такими как биполярное расстройство, депрессия, болезни Альцгеймера и Хантингтона. В данной работе представлены протоколы получения, очистки и рефолдинга внутриклеточного домена рецептора, а также показаны оптимальные условия для проведения структурных исследований методом ЯМР.

Нами были получены конструкции, кодирующие IR c двойными аминокислотными заменами: I951E-F952R; F956E-S957R; I960E-G961R. Мутации F956E-S957R; I960E-G961R не влияли на активацию инсулинового рецептора, а замена I951E-F952R приводила к автофосфорилированию рецептора даже при отсутствии лиганда. Предполагается, что двойная замена I951E-F952R приводит к стабилизации трансмембранного домена в активной конформации за счет образования солевых мостиков между глутаминовой кислотой и аргинином.

Данная работа посвящена разработке новой in vitro модели артериального тромбоза на основе гидрогеля. Разработанная модель отличается круглым сечением и возможностью создания сосудов крупного диаметра, соответствующих размерам артерий и крупных артериол. Конструкция модели позволяет проводить исследования в режиме реального времени и изучать образование тромбов в условиях артериальных скоростей течения человеческой крови.

Толл-подобные рецепторы (TLR) - паттерн-распознающие рецепторы врожденной иммунной системы. Для исследования механизмов активации рецепторов необходима структурная информация о данных молекулах. Структуру полноразмерного TLR определить не удаётся, но получается исследовать отдельные функциональные домены TLR. В данной работе была определена пространственная структура трансмембранного домена и примембранного гидрофобного региона TLR2, TLR3 и TLR9 человека.

The effect of phytochemicals from plant extracts of Russian origin on the reproductive activities of C. elegans was investigated. These plants are widely used historically as medicine across the globe, and recent research has demonstrated their usefulness in treating reproductive disorders as observed in some animal models. In this study, C. elegans was used for the first time as a model to show the efficacy of these phytochemicals and extracts from medicinal plants in reproductive activities.

Pharmacological study of the aphrodisiac activity of the plant piper from its essential oils to create a new drug formula in the form of lozenges.

SOS-ответ является одним из важнейших механизмов адаптации бактерий к условиям стресса, например, при воздействии на них антибактериальными препаратами. В данной работе была оценена концентрация белка SulA (ингибитор ключевого белка деления бактерий – FtsZ) в клетках, что в дальнейшем может помочь установить механизм его действия. В свою очередь, выяснение данного механизма может привести к созданию антибактериальных веществ - аналогов SulA с аналогичным механизмом действия.

Для проведения in vitro структурных исследований мембранных белков (МБ) их зачастую солюбилизуют в смесях органических растворителей с водой и переводят, например, в липид-детергентные бицеллы. Но детали этого процесса, как правило, не контролируются, и его условия подбираются эмпирически.
В данной работе исследовано поведение липид-детергентных смесей и модельного альфа-спирального МБ при различных полярностях растворителя, на основании чего были получены и протестированы методики рефолдинга МБ.

В работе была изучена способность различных металл-органических координационных полимеров (МОКП) сорбировать противоглаукомный препарат - бримонидин, а также пролонгировать его действие. Впервые была разработана платформа для доставки терапевтических препаратов в глаз на основе контактной линзы и МОКП, способная значительно улучшить биодоступность лекарств.

Данная работа посвящена разработке протоколов получения и изучению структурных особенностей трансмембранного домена одного из представителей семейства белков TLR - рецепторов иммунной системы, ответственных за распознавание патогенов и запуск каскадов реакций по защите организма.

Изучение механизма сборки вирусных частиц представляет интерес как для фундаментальной науки, так и для поиска новых лекарственных мишеней. Проведена визуализация внутриклеточного траффикинга М-белка SARS-CoV-2 с использованием коротких α-спиралей (K/E coils) и определена пространственно-временная динамика траффикинга экспрессируемого М-белка SARS-CoV-2 на ранних этапах созревания.

Ответ опухоли на таргетную терапию HER2-специфичными препаратами может зависеть от множества факторов, присутствующих в организме пациента. Мы показали, что сыворотка крови человека показывает существенно различающуюся в зависимости от конкретного донора возможность модулировать действие HER-таргетных препаратов.

Матриксы являются ключевым компонентом тканеинженерных конструкций, поскольку служат подложкой для прикрепления и роста клеток. В связи с этим целью данной работы было получение композитных пленок и макропористых гидрогелей на основе сополимеров хитозана с L, L – и L, D – олиголактидами; изучение их физико-химических свойств и структуры, а также пролиферации/дифференцировки на/в них животных клеток в модели in vitro.

Кислоточувствительные ионные каналы (ASIC) участвуют в различных, в том числе и патологических процессах организма. В работе был обнаружен и исследован новый модулятор ASIC1a каналов пептидной природы.

Нехватка доступных противовирусных препаратов широкого спектра действия ограничивает возможности лечения заболеваний, вызванных вирусами. Нами были получены гибридные наносистемы на основе золотых наночастиц и сульфонатных лигандов, обладающие высокой биосовместимостью и потенциальной вирулицидной активностью за счет ингибирования связывания вируса с клеткой.

В работе приведены сведения о морфологических изменений желёз Гардера при имплантации пленок полилактида в переднюю камеру глаза. Согласно полученным результатам, имплантация пленок полилактида в пережнюю камеру глаза сопровождается неравномерно выраженным изменениям желез Гардера, выраженным отеком стромы, полнокровием сосудов, снижением эпителиально-стромального соотношения.

Синтезированы функциональные структуры для биомедицинских применений в Фотодинамической терапии и Магнитно-резонансной томографии (тераностика). Возбуждаемые рентгеновским излучением металлоорганические сцинтилляторы использовали для создания комплексов с наноалмазами в целях получения оптически активных наноплатформ, способных доставлять молекулы фотосенсибилизатора в живые ткани в целях фотодинамической терапии.

От пациентов в острой фазе covid-19 были отобраны плазмабласты. Затем методом nested PCR были получены гены иммуноглобулинов от единичных плазмабластов. Продукты амплификации были секвенированы методом Сэнгера. Библиотека полученных сиквенсов была проанализирована и сравнена с данными NGS, чтобы найти аффинное антитела против RBD S-белка SARS-CoV-2.
Поскольку лучевая терапия остается основным методом лечения глиом, радиорезистенность клеток глиомы и мишеней для изменения их толерантности к облучению представляет значительный интерес. Понимание клеточных и молекулярных событий, лежащих в основе радиорезистентности и рецидива при мультиформной глиобластоме (ГБМ), затруднено из-за отсутствия доступа к резистентным клеткам от пациентов, подвергшихся лучевой терапии. В результате лечение ГБМ представляет собой серьезную проблему.

В этом исследовании с помощью высокопроизводительного скрининга были изучены новые антимикробные пептиды в транскриптомах 12 видов морских полихет и структура BRICHORS домена в их белках-предшественниках, а также проведен филогенетический анализ одного из новых антимикробных пептидов.

Разработан метод одновременной идентификации множества геномных маркеров на основе гибридизации анализируемых фрагментов ДНК изолятов N. gonorrhoeae на гидрогелевом микрочипе. Созданный подход предназначен для выявления мутаций в геноме N. gonorrhoeae, определяющих устойчивость как к актуальным препаратам для терапии гонореи - цефтриаксону и азитромицину, так и к ранее применявшимся пенициллину, тетрациклину и ципрофлоксацину. Построена регресионная модель для предсказания МПК цефтриаксона.

В работе предложен метод определения кластеризованного состояния липидов в модельных биологических мембранах ДОФХ/ДОФС по оценке локальной поверхностной плотности в окрестности полярных головок липидов.
Показано, что свойства мембраны, такие как плотность системы и коэффициент диффузии, зависят от липидного состава мембраны и различаются для кластеризованных и некластеризованных липидов.

Спортивная перегрузка – распространенное явление среди атлетов. Крайней формой спортивной перегрузки считается синдром перетренированности - хроническое, трудно поддающееся коррекции состояние. Исследование направлено на создание системы диагностики перегрузки, основыванной на оценке соотношений концентраций маркерных микроРНК в слюне на разных этапах тренировочного процесса. Использован разрабатываемый нами новый метод секвенирования, основанный на технологии нанопорового секвенирования.

Болезнь Альцгеймера - нейродегенеративное заболевание, одним из синдромов которой является образование амилоидных бляшек. На данный процесс влияет количество фосфорилированного бета-амилоида в организме. В данной работе исследуется метод определения доли фосфорилированного бета-амилоида c использованием MALDI-TOF.

В исследовании была показана необходимость дисульфидизомераз Agr для регенерации и возможность восстановления способности к регенерации при оверэкспрессии генов данного семейств путём проведения инъекций мРНК генов Agr в зародыш или при обработке их белковыми продуктами. Результаты показывают, что способность к регенерации восстанавливается как на морфологическом, так и на молекулярном уровне. Таким образом, в будущем данный подход может быть использован для улучшения регенерации у человека.

В данной работе рассмотрены преимущества использования эластичных нанопор вместо твердотельных аналогов для детектирования одиночных биологических макромолекул. Было исследовано, что перенос молекулы происходит под действием не электрофоретических, а пондеромоторных сил, что делает возможным транспортировку электронейтральных молекул и на 1-2 порядка увеличивает характерное время жизни молекулы внутри нанотрубки.

Данная работа посвящена исследованию механизмов действия антимикробных пептидов (АМП). С помощью метода патч-кламп мы установили механизмы регуляции формирования пор антимикробными пептидами мелиттином и магаинином-I.

Для исследования антирестрикционной активности ArdB против RM систем I класса трех различных семейств: EcoKI, EcoAIи EcoR124II были созданы штаммы, содержащие в себе гены соответствующих систем рестрикции-модификации, а также ген ardB под сильным регулируемым промотором. Полученные штаммы позволят исследовать концентрационные эффекты антирестрикционной работы белков семейства ArdB против систем рестрикции-модификации I типа.

В работе была проведена оценка влияния антирестрикционного белка ArdB на активность рестриктазы EcoAI. По результатам исследования была выявлена относительно слабая антирестрикционная активность данного белка в отношении EcoAI, что скорее всего объясняется тем, что ArdB активен в отношении EcoAI, однако выявленный экспериментально уровень активности был низким из-за недостаточной экспрессии ArdB с использованной плазмиды pTZArdB.

В данной работе ведется исследование влияния микроэлементов (Zn, Se, Mg), добавленных вместе с культуральной средой для культивирования базидиомицетов, на биосинтез противораковых метаболитов. Выявление корреляций позволит создать базу данных, которая позволит разработать полезную пищевую добавку.

В настоящее время на территории России всё чаще встречается туберкулёз с широкой лекарственной устойчивостью, для терапии которого применяются новейшие препараты. В работе был проведен генетический анализ возбудителя туберкулеза как от впервые выявленных пациентов, так и от пациентов с неудачным исходом лечения. Разработан метод быстрого генотипирования доминирующей в РФ линии Beijing на биологических микрочипах, позволяющий перейти к персонализированной терапии туберкулёза.

Работа посвящена выделению митохондрий из печени мышей и использованию их для доставки магнитных наночастиц к органам. Частицы связывались с поверхностью митохондрий и вводились в кровотоке, после чего изучалось биоораспределение с помощью спектральной магнитометрии.

Использование наночастиц является одним из перспективных направлений тераностики. Основным препятствием для применения наноматериалов в медицинской практике является малое количество методов их доставки в клетки организма. Нами был создан новый способ транспортировки наночастиц, основанный на использовании изолированных митохондрий.

В данной работе методами ЯМР-спектроскопии исследуется пространственная структура липогликопептидного антибиотика "Гауземицин B". Произведено отнесение сигналов протонов липогликопептида в воде, в окружении мицелл SDS, а также в окружении мицелл DPC в присутствии ионов кальция. С помощью программы CYANA рассчитаны структуры мономеров Гауземицина B в мицеллах SDS и DPC. Определена ранее неизвестная хиральность двух нестандартных остатков в N-концевом участке пептида.

Среди множества онкомаркеров одним из наиболее значимых является HER2-рецептор, член семейства EGFR. Гиперэкспрессия данного рецептора часто коррелирует с высоким метастатическим потенциалом опухоли, а также с устойчивостью к действию химиотерапии и высоким риском рецидива.
Целью данной работы является получение наночастиц магнетита, сочетающих в себе терапевтические и диагностические свойства, для адресного воздействия на HER2-положительные опухоли.

Одним из классических тестов по оценке жизнеспособности клеток по биохимическим процессам является МТТ-тест. Изначально данный тест разрабатывался для оценки цитотоксчного действия на здоровые клетки человека. Но возникает вопрос: насколько подходит данный метод для оценки жизнеспособности различных опухолевых клеток?
Целью данной работы: сравнить эффективность использования МТТ-теста для определения цитотокичности доксорубицина и гамма-излучения МТТ-теста на культуры опухолевых клеток

Пористый кремний представляет собой материал с уникальными физико-химическими и биологическими свойствами. В настоящей работе изучены процессы растворения нанокристаллов кремния при их инкубации в модельной жидкости и живых клетках рака молочной железы MCF-7 методом спектроскопии комбинационного рассеяния света. Результаты работы будут использованы для разработки систем доставки лекарств на основе наночастиц кремния и разработки новых подходов в тераностике заболеваний.

Статья посвящена очистке воды и способам улучшения ее показателей, что является актуальной задачей современности. Различают несколько степеней очистки: механическую,физико-химическую; биологическую. Очищенная вода должна соответствовать нормативным требованиям и пройти биологическую реабилитацию. Биологическая очистка - это процесс восстановления воды до естественного состояния при помощи водорослей, рассмотрим применения штамма Chlorella с этой целью.

Целью настоящего исследования был сравнительный анализ адгезии и выживаемости HEK293Т на различных полилактидных матриксах с губчатой, нетканой волокнистой и пленочной структурой. В ходе исследования было показано влияние покрытия поверхности матриксов полиаминами, в частности, полиэтиленимином, на адгезию клеток. Изучение воздействия морфологии поверхности матриксов на адгезию клеток осуществлялось методом иммуногистохимического окрашивания с последующей конфокальной микроскопией.

Была разработана методика получения белковых наночастиц на основе иммуноглобулинов, показаны применения для таргетной терапии раковых клеток, визуализации наночастиц in-vivo с помощью флуоресцентной томографии и магнитно-резонансной томаграфии

В рамках данной работы был изучен полиморфизм 8 микросателлитных локусов винограда в 73 образцах с целью оценить потенциал применения этих локусов как маркеров при паспортизации винограда. Для этого на основе данных фрагментного анализа была произведена кластеризация в программе Structure, результаты были проанализированы и сопоставлены с существующими теоретическими представлениями.

Вспышки инфекций, вызванные вирусами, приводят к серьезным глобальным проблемам в области здравоохранения и экономики, во многом из-за отсутствия специфического лечения. Таким образом, очевидна острая необходимость в новых противовирусных препаратах. В данной работе было проведено исследование спектра противовирусной активности 5-(перилен-3-илэтинил)урацила и его производных по отношению к репродукции оболочечных вирусов.

В данной работе была исследована способность аналогов хромофора GFP ингибировать репродукцию ВИЧ-1, основанная на стабилизации LTR-III ДНК G4.

В данной работе проводится тестирование и оптимизация работы новой структуры на основе бинарного ДНКзима для детекции ДНК- или РНК-последовательностей аналита. Данная структура позволит понизить фоновый флуоресцентный сигнал от репортерной пробы, что повысит чувствительность детекции аналита.

Биосовместимые сенсоры для измерения рН в клетке используются в исследованиях патогенеза нейродегенеративных и онкологических заболеваний. Мы предлагаем дизайн такого рН-сенсора на основе цитозин-богатых квадруплексов - i-мотивов. Было показано, что введение алкильной модификации в петли i-мотива сдвигает рабочий диапазон сенсора в область физиологических значений рН и ускоряет его отклик. Также была проведена калибровка сенсоров на клетках и определено значение рН в клеточных ядрах.

В работе предложена адаптация метода DirectMS1 ультрабыстрой хроматомасс-спектрометрии с использованием пятиминутных градиентов и регистрацией масс-спектров первого уровня для метапротеомных исследований. Разработан алгоритм идентификации бактерий при помощи поиска по белковым базам данных. Предложена методика определения количественных соотношений микроорганизмов в модельных микробиомах.

В работе обсуждается возможность использования метода ИК-Фурье спектроскопии для анализа пищевой спиртосодержащей продукции. Метод позволяет быстро и с относительно высокой точностью получить информацию о наличии или отсутствии в составе токсичных ядовитых веществ, концентрацию этанола в растворе, и наличие ароматических веществ задающих требуемые органолептические характеристики продукта. Преимущества - скорость, малый объем проб, селективность и отсутствие предварительной пробоподготовки.
Энтеровирус A71 (EV-A71) является одним из этиологических агентов синдрома рука-нога-рот (HFMD), но в некоторых случаях может приводить к развитию тяжелых неврологических заболеваний. Из-за отсутствия эффективных лекарств для подавления инфекции EV-A71 разработка противовирусных средств является актуальной задачей нашего времени. В данном исследовании была проведена оценка противовирусной активности серии производных N6-бензиладенозина (ингибиторов репликации энтеровируса А71).

Аутофлуоресценция тканей является одной из основных проблем иммунофлуоресценции. Аутофлуоресценция приводит к получению некачественных изображений и затрудняет анализ данных. Ткань надпочечников мыши излучает интенсивную аутофлуоресценцию, что затрудняет определение специфических сигналов иммунофлуоресценции. В данной работе мы протестировали способность различных химических обработок к снижению автофлюоресценции срезов надпочечников без негативного воздействия на флуоресцентные метки.

Нарушения в функционировании рецептора RAGE связаны с развитием болезни Альцгеймера, диабета, сердечно-сосудистых, онкологических заболеваний. Данная работа описывает разработку протоколов получения и очистки трансмембранного домена RAGE для изучения структурных особенностей.

В данной работе изучены методы синтеза потециальных фотосенсибилизаторов для антимикробной фотодинамичсекой терапии, а также проведена сравнительная характеристика антибактериальной активности симметричных и асимметричных катионных производных мезо-арилпорфиринов в отношении суспензий и биопленок S.aureus и E.coli.

В работе проведен комплексный анализ экспрессии маркеров дифференцировки кератиноцитов (Krt8, Krt5, Krt10, Inv), а также выявлена временная и пространственная динамики их взаимной локализации в ходе эмбрионального развития кожи лабораторных мышей (на стадиях E8, E9, E11 и E13) – классической модели исследования биологии кожных покровов человека.
Клетки лимфомы Беркитта характеризуются нарушением регуляции прото-онкогена c-Myc вследствие его хромосомной транслокации. Часто ген c-Myc транслоцируется в локус тяжёлых цепей иммуноглобулинов и может попадать под влияние энхансерных РНК данного локуса. В данной работе демонстрируется, что энхансерная РНК AL928768.3 может влиять на экспрессию онкогена с-Myc и на клеточную пролиферацию в клетках лимфомы Беркитта.

Были разработаны программируемые ДНК структуры (бинарная антисмысловая ДНК система и ДНК-машина) с целью селективного подавления целевой матричной РНК только в опухолевых клетках с разными длинами РНК-связывающих рук (15/15 и 8/10 нуклеотидов). В качестве модельной системы мы использовали клетки хронического миелоидного лейкоза (К562), трансформированные плазмидой для экспрессии зеленого флюоресцентного белка (GFP) (K562/GFP). Были определены степень селективности и эффективности ДНК машин.

Показано, что в открытых системах инактивация фермента в процессе реакции приводит к двухфазным ответам на повышение концентрации субстрата или ингибитора (уровень продукта сначала повышается, а затем понижается до нового стационарного уровня, или наоборот). В отсутствие инактивации эти ответы однофазные (уровень продукта монотонно изменяется до нового стационарного уровня). Таким образом, фактор инактивации играет важное значение в регуляции уровня биологически активных метаболитов в организме.

Среди многообразия экстремофильных организмов на сегодня особое внимание уделяется лишайникам. Их стрессовая устойчивость обусловлена наличием в составе лишайников уникальных вторичных метаболитов. По результатам современных исследований, наряду с лишайниковыми веществами в адаптации лишайников к неблагоприятным условиям среды важную роль играет меланин.

В данной работе было исследовано участие генов энол-ацил протеинредуктазы, а также генов MSMEG_5597, MSMEG_4427 и MSMEG_1963 в формировании устойчивости Mycobacterium smegatis к триптантринам - природному антибиотику с широким спектром биологической активности.

Мы предлагаем использовать анализ кинетики восстановления генетически кодируемого биосенсора перекиси водорода HyPer (Belousov et al. 2006) для количественной оценки активности тиол-восстанавливающих систем в живых клетках.
В результате применения предлагаемой методики выяснилось, что в цитоплазме клеток K562 HyPer восстанавливается Trx-системой. Кроме того, оказалось, что при окислительном стрессе эффективность восстановления HyPer в клетках K562 резко падает.

В данном исследовании нами рассматривается возможная роль эволюционно консервативного АТФ-зависимого фактора ремоделирования хроматина CHD1 (Chromo-ATPase/Helicase-DNA-binding protein 1) в дозовой компенсации у плодовой мушки Drosophila melanogaster.

Массовое тестирование на нейтрализующие антитела позволяет оценить коллективный иммунитет, а также проверить эффективность вакцин на стадии клинических испытаний. Текущий золотой стандарт - это обычный тест на нейтрализацию вирусов, требующий наличия живых патогенов и лаборатории с уровнем биобезопасности 3. Суррогатный тест вирус нейтрализации может быть проведен в формате обычного ИФА и сводиться к измерению уровня ингибирования взаимодействия RBD SARS-CoV-2 и внеклеточного домена АПФ2.

Аденоассоциированные вирусные векторы (ААВ) являются ведущей платформой для доставки генетического материала при генотерапиях различных заболеваний человека. В нашей работе мы исследуем 18 различных химерных AAВ капсидных белков in vitro и in vivo.
В данной работе предложен интерференционный биосенсор, позволяющий определять взаимодействие ДНК-олигонуклеотидов, а также измерять кинетику взаимодействия. На поверхности биочипа был сорбирован биотинилированный олигонуклеотид, с которым связывалась комплементарная последовательность в промывающем растворе. Предложенный сенсор прогнозируемо позволяет измерять термодинамические и кинетические характеристики связывания с полностью и частично комплементарными последовательностями.

Нитрозильные комплексы железа (НКЖ) являются стабильной формой существования монооксида азота (NO) в организме. Согласно литературным данным, одной из основных мишеней действия НКЖ in vivo является транспортный белок крови альбумин. Поэтому целью данной работы стало изучение взаимодействия НКЖ с тиокарбамидными лигандами с бычьим сывороточным альбумином.

Колбочковая дистрофия с сверхнормальным откликом палочки (CDSRR) - аутосомно-рецессивное заболевание, которое приводит к прогрессирующей дегенерации сетчатки.
Индуцированные плюрипотентные стволовые клетки (ИПСК) получают из клеток крови пациентов. Затем ткань сетчатки (органоиды) дифференцируют от ИПСК с использованием трехмерной стратегии в большом количестве. Эти органоиды можно эффективно использовать для нацеливания клеток-доноры AAV, а также для моделирования заболеваний.

Появляются свидетельства того, что белки-ингибиторы защитных систем прокариот могут быть распространены так же широко, как и системы иммунитета хозяина. При этом некоторые из них могут влиять на активность сразу нескольких типов защиты. В этой работе мы проверили коллекцию известных анти-рестрикционных белков, активных против системы рестрикции-модификации типа I, на их способность ингибировать совершенно другую систему иммунитета - CRISPR-Cas типа I–E из Escherichia coli.

Для устранения двунитевых разрывов ДНК существует несколько репарационных механизмов: гомологичная рекомбинация (HR), однонитевый отжиг (SSA), канонический и альтернативный пути негомологичного воссоединение концов (NHEJ). Точное восстановление нуклеотидной последовательности обеспечивает механизм HR. Центральную роль в HR играет белок RAD51, его паралоги участвуют в сборке Rad51-филамента. Данная работа посвящена функциям гена Rad51D у дрозофилы.

Целью нашей работы было изучение влияния мутаций в гене инсулина, выявленных в ходе молекулярно-генетического исследования у детей с ПНСД и диабетом MODY, на экспрессию и процессинг препроинсулина. Были исследованы варианты с однонуклеотидными заменами в интроне 2 гена инсулина человека, а также вариант с миссенс-мутацией в последовательности, кодирующей сигнальный пептид.

A modified vaccine strain of poliovirus type 1 (Sabin) was created, in which the internal ribosome entry site (IRES) was replaced with the IRES of human rhinovirus type 2.We have developed a recombinant strain based on the vaccine strain of poliovirus type 3, the IRES of a non-pathogenic strain of living enterovirus vaccine LEV14, for which high specific cytotoxicity against tumor cells was shown. This virus named Russo successfully passed safety tests even for chronic toxicity.

Известно, что фибриноген является в 20 раз более чувствительным к окислительной модификации по сравнению с другими белками плазмы крови.Методом масс-спектрометрии были проанализированы образцы неокисленного и обработанного 300 мкМ Н2О2 и 50 мкМ HOCL фибриногена. Аминокислотные остатки, локализованные в области Е, которые участвуют в связывании тромбина, не были подвержены окислительной модификации, что указывает на сохранение тромбин-связывающих сайтов молекулы фибриногена при окислении.

Основной целью данного проекта являлось создание нового материала, обладающего большой сорбционной емкостью и биосовместимостью, а также имеющего магнитные свойства, и последующее его исследование в качестве сорбционного агента для лекарств.
Одно из важнейших применений поли-гамма-глутаминовой кислоты (ПГК) - адресная доставка лекарственных препаратов. Степень проявления способности ПГК связывать катионы варьирует в зависимости от строения: молекулярной массы и состава оптических изомеров, определяющих вторичную структуру. Разработан дизайн эксперимента, впервые описано влияние состава питательной среды продуцента на структуру ПГК. Такой подход необходимо использовать в биотехнологии ПГК для рационального дизайна препаратов.

Бактериофаг λ_2B8 обладает очень высокой степенью сходства генома и морфологии вириона с фагом λ, однако его адсорбционный аппарат имеет иное устройство. В ходе данной работы исследован характер роста фага λ_2B8 на различных бактериальных штаммах, определен спектр хозяев этого фага, изучена его кинетика адсорбции, описана морфология вирионов, получены новые данные об адгезинах λ_2B8, создана генетическая конструкция для дальнейших экспериментов.

В работе использовали мембранные фракции бактерий Gluconobacter oxydans sbsp. Industrius ВКМ-1280, а также ферменты алкогольоксидазу и глюкозооксидазу. Применение наноматериала ТРГ позволяет значительно улучшать электрохимические характеристики биосенсоров, что дает возможность их применения для создания биосенсоров второго и третьего поколения для детекции глюкозы и этанола.

The increasing population growth in Nigeria, calls for a focused research directed towards the study of underexploited legumes especially those that could adapted to our adverse environmental conditions with high resistant to disease and pest. Pulses have been known for its supplies of energy, vitamins and mineral and its protein supply. Therefore, a study on evaluation of nutritional profile of Ethiopian Lima Bean and other legumes found Africa is important asap winning the war on hunger.

This work is targeted towards determining the proximate composition of the thirteen accessions of Lima Bean found in Ethiopia and the production of Lima Bean. Further research especially on genetic improvement for easy distribution and availability of cultivated germplasms among farmers in Ethiopia, the use of grounded seed as a major ingredient in our confectionery industry and as animal feed around Globally is also recommended if the battle against malnutriution and hunger must be won...

В данной работе проанализирован спектр мутаций гена-супрессора VHL в образцах рака почки с различными клинико-гистологическими характеристиками. Исследование проведено на двух выборках пациентов, одна из которых является непредвзятой, а для другой ранее был охарактеризован профиль миРНК. Анализ выборок выявил различия в клиническом течении заболевания в зависимости от нарушений в гене-супрессоре VHL, либо профиле миРНК и так же зависимость мутационного статуса от профиля миРНК.

Статья посвящена синтезу и исследованию цитотоксической активности 2-амино-1-(4-бромфенил)-5-(3,3-диметил-2-оксобутилиден)-4-оксо-4,5-дигидро-1Н-пиррол-карбоксамида на культурах опухолевых клеток HCC 1806 MDA-MD-231 рака молочной железы, H1299 немелкоклеточного рака легкого, РС-3 рака предстательной железы. Была изучена ингибирующая концентрация соединения, которая превышает эталон сравнения - паклитаксел. Острая токсичность соединения составила ЛД 50 более 1000 мг/кг.

Была получена конструкция биосенсора, расположенная на плазмидном векторе, для детекции концентраций валина в клетках Corynebacterium glutamicum. Биосенсор состоит из гена флуоресцентного белка YFP под контролем промотора гена brnFE, и гена Lrp регулятора. Было показано, что увеличение флуоресценция клеток, содержащих плазмидный вектор, совпадает с увеличением продукции валина клетками и при помощи конструкции биосенсора возможно изучение путей биосинтеза валина.

Были отработаны условия эффективной доставки нуклеиновых кислот in vivo с использованием плазмид (phMGFP, рDNA_RBD и мРНК-GFP) на самках мышей линии Balb/с с помощью метода электропорации. Было показано, что при трех импульсах прямой и обратной полярности с контролируемым сопротивлением достигается наибольший уровень продукции белка в иммунизированных животных.